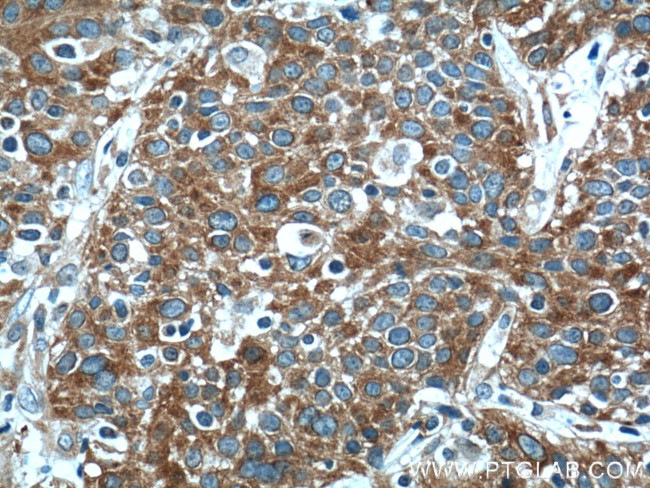
FUT4 Antibody in Immunohistochemistry (Paraffin) (IHC (P))

Search
Proteintech
FUT4 Polyclonal Antibody
{{$productOrderCtrl.translations['antibody.pdp.commerceCard.promotion.promotions']}}
{{$productOrderCtrl.translations['antibody.pdp.commerceCard.promotion.viewpromo']}}
{{$productOrderCtrl.translations['antibody.pdp.commerceCard.promotion.promocode']}}: {{promo.promoCode}} {{promo.promoTitle}} {{promo.promoDescription}}. {{$productOrderCtrl.translations['antibody.pdp.commerceCard.promotion.learnmore']}}
产品信息
19497-1-AP
种属反应
已发表种属
宿主/亚型
分类
类型
抗原
偶联物
形式
浓度
规格
纯化类型
保存液
内含物
保存条件
运输条件
产品详细信息
19497-1-AP antibody detects the native band around 59 kDa and glycosylated isoform proteins around 95-140 kDa in SDS-PAGE.
靶标信息
FUT4 (Fucosyltransferase 4) is a Protein Coding gene. Diseases associated with FUT4 include Colon Adenocarcinoma and Liver Lymphoma. Among its related pathways are Glycosphingolipid biosynthesis - lacto and neolacto series and Mannose type O-glycan biosynthesis. Gene Ontology (GO) annotations related to this gene include fucosyltransferase activity and alpha-(1->3)-fucosyltransferase activity. The product of this gene transfers fucose to N-acetyllactosamine polysaccharides to generate fucosylated carbohydrate structures. It catalyzes the synthesis of the non-sialylated antigen, Lewis x (CD15).
仅用于科研。不用于诊断过程。未经明确授权不得转售。
生物信息学
蛋白别名: 3-fucosyl-N-acetyl-lactosamine epitope; 4-galactosyl-N-acetylglucosaminide 3-alpha-L-fucosyltransferase; alpha (1,3) fucosyltransferase, myeloid specific; alpha (1,3) fucosyltransferase, myeloid-specific; alpha 1,3-fucosyltransferase; Alpha-(1,3)-fucosyltransferase 4; ELAM ligand fucosyltransferase; ELAM-1 ligand fucosyltransferase; Fuc-TIV; Fucosyltransferase 4; Fucosyltransferase IV; fucT-IV; Galactoside 3-L-fucosyltransferase; Lewis X; stage-specific embryonic antigen 1
基因别名: AI451562; CD15; ELFT; FAL; FCT3A; FUC-TIV; FucT-IV; FUT4; FUTIV; LeX; SSEA-1; Ssea1
UniProt ID: (Human) P22083, (Mouse) Q11127
Entrez Gene ID: (Human) 2526, (Mouse) 14345